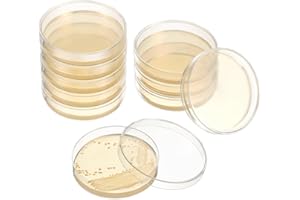
FELTECHELECTR 20pcs Pre-Poured Agar Plates for Laboratory Use Nutrient Agar Petri Dishes for Science Experiments Easy to Use Culture Medium for School Projects and Research

FELTECHELECTR best sellers
Get a list of 38 FELTECHELECTR best sellers on Walmart and Amazon . Period is past 7 days, last updated 2025-01-06.
|
#1 20pcs Pre Poured Agar $32.99 on Amazon |
|

|
#2 🔥 🆕 FELTECHELECTR Construction $13.68 on Walmart |
|

|
#3 4pcs Mini Haystack Mini $10.79 on Amazon |
|

|
#4 10pcs Clothes Hanger $16.51 on Amazon |
|

|
#5 Film Case with Large $11.29 on Amazon |
|

|
#6 Sudoku Game 1 Set Kids $21.85 on Amazon |
|

|
#7 2Pcs Manual Inverted $11.99 on Amazon |
|

|
#8 Large Plastic Trash Can $17.10 on Amazon |
|

|
#9 Poker Wheel Table Game $22.99 on Amazon |
|

|
#10 Denture Model 1 Set Model $12.59 on Amazon |
|

|
#11 Car Seat Tray for Travel $6.66 on Amazon |
|

|
#12 Turntable Wheel of Fortunes $12.59 on Amazon |
|

|
#13 Medical Model Anatomical $13.12 on Amazon |
|

|
#14 1 Box Peel Off China $7.09 on Amazon |
|

|
#15 8 pcs Miniature Figurine $28.39 on Amazon |
|

|
#16 Candy Machine Gear $21.99 on Amazon |
|

|
#17 FELTECHELECTR Pink Foldable $8.59 on Walmart |
|

|
#18 FELTECHELECTR 1 Set Ukulele $5.05 on Walmart |
|

|
#19 FELTECHELECTR 11 Pcs $20.08 on Walmart |
|

|
#20 FELTECHELECTR 50Pcs Blue $5.59 on Walmart |
Suggested best sellers
What's in Bestsellers.ai PRO ?
- 📊 Product Sales Estimates
- 💰 Total Sales Estimates
- 📜 Product Sales history
- 📅 52-Week Sales estimates
- 🔍 Advanced filtering
- ♻️ Second Hand and Refurbished market Data
Who uses Bestsellers.ai PRO ?
Trusted by e-merchants everywhere, Bestsellers.ai is their go-to for deciding what to sell next. Leading brands and retailers rely on us for crucial competitor insights and data-driven choices. 🚀
